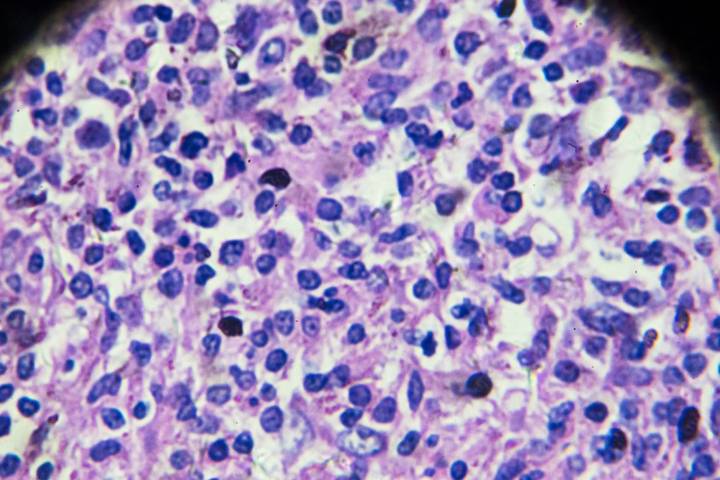
Virtual Diet and Exercise Program May Lessen Lymphoma Treatment Side Effects

New research from the Sylvester Comprehensive Cancer Center suggests that a virtual program centered on diet and exercise may help patients better tolerate chemotherapy for lymphoma and remain on schedule with their prescribed regimens. Early results of this form of intervention were derived from the Lifestyle Intervention of Food and Exercise for Lymphoma Survivors (LIFE-L) randomized clinical trial, which is evaluating whether lifestyle support delivered during chemotherapy can reduce the side effects from lymphoma therapies that are known to interfere with ongoing, prescribed treatments.
Early findings from LIFE-L will be presented at the American Society of Hematology annual meeting in Orlando this week. The researchers sought to develop and test this intervention spelled out in LI

Inside Precision Medicine
The Atlantic
Raw Story
CNN Politics
Press of Alantic City Business
People Top Story
RadarOnline